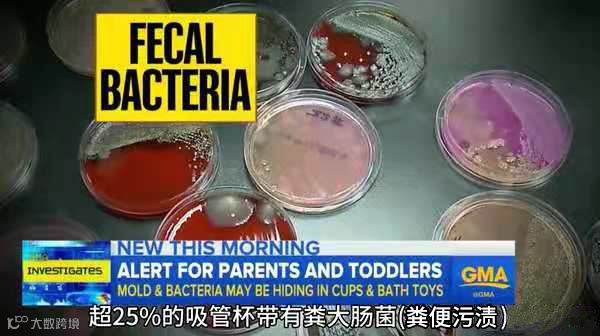

对孩子来说,
最开心的时光莫过于玩玩具的时候~
但如果父母没有把玩具清洁到位,
那么最开心的时光就可能最危险!

孩子的健康是每一位爸爸妈妈都无比关心的问题,从奶瓶到玩具,每天洗了又刷,生怕一个不小心病从口入。

然而宝宝餐椅、玩具等物品材质特殊,
清洁起来表面干净很容易,
彻底除菌消毒却比较难,
需要爸爸妈妈们格外注意咯~
当您看到宝宝在桌面上、玩具上乱涂乱画,或将颜料和记号笔不小心画在了课桌上,既影响整体美观,又不卫生;您一定很苦恼吧?

日常中塑料表面污渍有快速处理方法吗?
1.用漂白水清洗,会使塑料褪色,让它失去鲜艳的颜色!
2.用钢丝球清洗,产生刮痕;后期更容易积污渍,还滋生细菌!
3.用刷子和抹布清洗,去污能力不强,老师清洗就会费时费力!

现在目前的家务活可能仅限一周一次大打除。宝宝的玩具、桌椅呢,清洗的次数也比较少,每次收拾都是把所有玩具聚拢到一起,等下次宝宝拿起来继续再玩。就算洗的话也只是用清水冲一冲,日常用的一些洗涤剂、清毒液不太敢用来给他洗玩具。

前段时间一篇文章彻底改变了我对宝宝玩具随便洗洗就行的想法。美国ABC电视台做了一个关于鸭嘴杯和橡胶玩具等与水接触的儿童生活用品的污染调查与检测。这些送检的水杯和玩具,100%都已经被霉菌污染,1/4的鸭嘴杯/吸管杯上都有粪便!而且据说“把消毒过的玩具给宝宝玩10天以后,塑料玩具上的细菌集落数可达3000多个,木制玩具上达近5000个,而毛皮制作的玩具上竟多达2万多个。”

看到这里相信大家也注意到了
清洁玩具很重要,而要想真的够干净
一定要用专用的玩具清洁剂!

吓得我赶紧上网去找靠谱的宝宝玩具桌椅清洁剂,看了一通发现,目前这方面比较靠谱的牌子是陌莎,植物为原料的清洁剂,相对让人放心,身边的宝妈基本推荐的也是它。

推荐亲一款适合儿童快速清洗塑料表面污渍的产品
陌莎-儿童玩具座椅清洁剂

陌莎品牌:
陌莎,是一家以家庭清洁和衣物清洁为主的品牌,品牌入驻CCTV7央视广告,品牌在京东商城排名前五,其每个产品都是经过多种环境进行测试,经过国家认证,检测后才开始发布上架销售!

现在孩子们的玩具越来越多,
尤其小宝宝还喜欢啃玩具,
但是传统清洁方式只能达到表面干净
完全无法彻底消毒杀菌!

陌莎-儿童玩具座椅清洁剂产品特性:
1、高效除菌:科学高效灭杀细菌
2、植萃配方:源于植物,多项零添加
3、安全无毒:温和不刺激,关注宝宝健康
4、无残留,免冲洗:无需水洗,随时随地清洁
5、培养小孩子从小爱做家务的好习惯


陌莎和很多知名品牌一样
非常注重环保安全,
原材料全部提取自天然植物成分(茶树精油/椰油提取物/小苏打等),
清洁杀菌的同时无添加伤害~

我们经过了“一次完整皮肤刺激实验和杀菌抗菌测试”
一次完整皮肤刺激实验,检测结果都为“0”
杀菌抗菌测试,检测结果为99%杀菌


(目前入口无伤害的检测报告正在进行检测中)
除此之外也特别设计了安全开口,
使用儿童安全锁扣设计,
在家长的照看下,帮宝宝打开安全锁扣,宝宝才能进行自己清洁~

宝宝餐椅、玩具等物品都经常接触孩子
方便学习成长的同时却也有潜在危害
而这款来自陌莎儿童玩具桌椅清洗剂就是爸爸妈妈们保护孩子最好的选择~
不止能把小孩接触的玩具清洁杀菌干净,还能从小给小孩培养爱做家务的好习惯~


适用范围广
除了可以清洗玩具,还可以清洗餐椅,厨房台面,宝宝爬爬垫、地板等等。

正确打开方式:
1、按下喷头右侧“ON”锁扣;
2、直接喷洒于物体表面,再用干净的湿毛巾擦拭即可;
3、用于除菌时,等待5min再擦拭。

不拘一格的产品用途:
适用范围 儿童玩具、餐桌、手推车、床架等用品;
家具、床柜、台面、家电等家居用品表面

省时省力省心又省钱,清洁一次,长效防护,减少孩子沾染
细菌的机会,用过的朋友都说好!


陌莎致力于为中国家庭提供全球好物,每个产品都经过层层筛选与对比,最终挑选出品质最优、性价比最高的产品,请大家放心使用!


